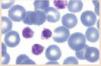

Deep vein thrombosis (DVT) of the limbs is a common disease and causes significant morbidity and mortality. It is frequently the prelude to pulmonary embolism (PE), it can recur in 30% of patients and in 25–40% of cases they can develop post-thrombotic syndrome (PTS), with a significant impact in functional status and quality of life. This document contains the recommendations on the diagnosis and treatment of acute DVT from the Thromboembolic Disease group of the Spanish Society of Internal Medicine (SEMI).
PE and thrombosis of unusual venous territories (cerebral, renal, mesenteric, superficial, etc.) are outside its scope, as well as thrombosis associated with catheter and thrombosis associated with cancer, which due to their peculiarities will be the subject of other positioning documents of the Thromboembolic Disease group of the Spanish Society of Internal Medicine (SEMI).
La trombosis venosa profunda (TVP) de miembros es una enfermedad frecuente y conlleva una morbimortalidad importante. Es, con frecuencia, la antesala de la embolia de pulmón (EP), puede recurrir en el 30% de los pacientes y en el 25–40% de los casos pueden desarrollar el síndrome postrombótico (SPT), con un importante impacto funcional y en la calidad de vida. En este documento se recogen las recomendaciones sobre el diagnóstico y tratamiento de la TVP aguda del grupo de Enfermedad Tromboembólica de la Sociedad Española de Medicina Interna (SEMI). Quedan fuera del alcance del mismo la EP y las trombosis de territorios venosos inusuales (cerebral, renal, mesentérica, superficiales, etc.), así como la trombosis asociada a catéter y la asociada a cáncer, que por sus peculiaridades serán objeto de otros documentos de posicionamiento del grupo de Enfermedad Tromboembólica de la Sociedad Española de Medicina Interna (SEMI).
Article
Diríjase desde aquí a la web de la >>>FESEMI<<< e inicie sesión mediante el formulario que se encuentra en la barra superior, pulsando sobre el candado.

Una vez autentificado, en la misma web de FESEMI, en el menú superior, elija la opción deseada.

>>>FESEMI<<<